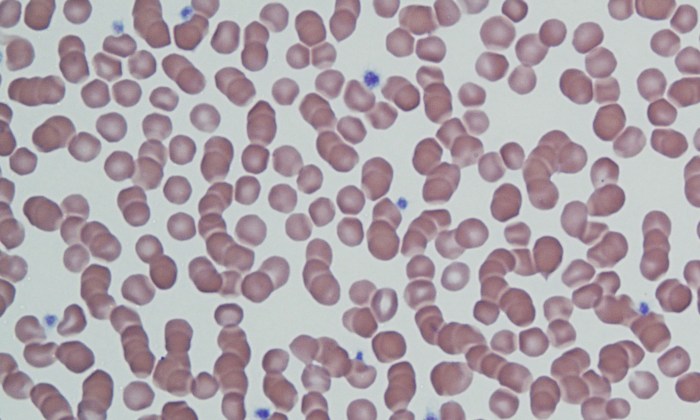
Rouleaux 4 (Feline 4)

Rouleaux

Morphology: stacks of red blood cells (like a stack of coins).
Look alike: agglutination. Rouleaux can be distinguished from agglutination with a saline dilution test: place one drop of blood on a slide, add 4 – 10 drops of 0.9% NaCl, examine the slide as a wet mount with a coverslip. Saline dilution will disperse rouleaux but not agglutination.
Clinical relevance: normal in healthy cats and healthy horses. Presence of rouleaux in dogs and cattle, or excessive rouleaux in cats and horses, indicates hyperglobulinemia (inflammation, neoplasia, renal disease).